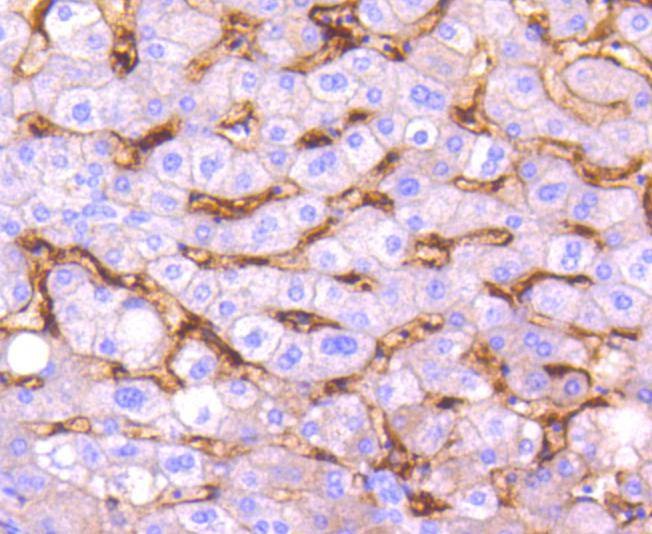
verifiedActivity

购物车
 您的购物车当前为空
您的购物车当前为空
Anti-CD14 Antibody (7E908) 是一种 Rabbit 抗体,靶向 CD14。Anti-CD14 Antibody (7E908) 可用于 ICC,IHC,WB。
别名 monocyte differentiation antigen CD14, CD14 molecule, CD14 antigen
Anti-CD14 Antibody (7E908) 是一种 Rabbit 抗体,靶向 CD14。Anti-CD14 Antibody (7E908) 可用于 ICC,IHC,WB。
| 规格 | 价格 | 库存 | 数量 |
|---|---|---|---|
| 50 μL | ¥ 1,495 | 5日内发货 | |
| 100 μL | ¥ 2,495 | 5日内发货 |
TargetMol的所有产品仅用作科学研究或药证申报,不能被用于人体,我们不向个人提供产品和服务。请您遵守承诺用途,不得违反法律法规规定用于任何其他用途。
| 产品描述 | Anti-CD14 Antibody (7E908) is a Rabbit antibody targeting CD14. Anti-CD14 Antibody (7E908) can be used in ICC,IHC,WB. |
| 别名 | monocyte differentiation antigen CD14, CD14 molecule, CD14 antigen |
| Ig Type | IgG |
| 克隆号 | 7E908 |
| 反应种属 | Human |
| 验证活性 | 1. Western blot analysis of CD14 on different lysates using anti-CD14 antibody at 1/1,000 dilution. Positive control: Lane 1: Human liver, Lane 2: SW480. 2. Immunohistochemical analysis of paraffin-embedded human uterus tissue using anti-CD14 antibody. Counter stained with hematoxylin. 3. Immunohistochemical analysis of paraffin-embedded human tonsil tissue using anti-CD14 antibody. Counter stained with hematoxylin. 4. Immunohistochemical analysis of paraffin-embedded human liver tissue using anti-CD14 antibody. Counter stained with hematoxylin. 5. Immunohistochemical analysis of paraffin-embedded human colon cancer tissue using anti-CD14 antibody. Counter stained with hematoxylin. 6. Immunohistochemical analysis of paraffin-embedded human spleen tissue using anti-CD14 antibody. Counter stained with hematoxylin. 7. ICC staining CD14 in A549 cells (green). The nuclear counter stain is DAPI (blue). Cells were fixed in paraformaldehyde, permeabilised with 0.25% Triton X100/PBS. 8. ICC staining CD14 in NCCIT cells (green). The nuclear counter stain is DAPI (blue). Cells were fixed in paraformaldehyde, permeabilised with 0.25% Triton X100/PBS. 9. ICC staining CD14 in NIH/3T3 cells (green). The nuclear counter stain is DAPI (blue). Cells were fixed in paraformaldehyde, permeabilised with 0.25% Triton X100/PBS. 10. ICC staining CD14 in LO2 cells (green). The nuclear counter stain is DAPI (blue). Cells were fixed in paraformaldehyde, permeabilised with 0.25% Triton X100/PBS. |
| 应用 | ICCIHCWB |
| 推荐剂量 | WB: 1:1000-2000; IHC: 1:50-200; ICC: 1:50-200 |
| 抗体种类 | Monoclonal |
| 宿主来源 | Rabbit |
| 构建方式 | Recombinant Antibody |
| 纯化方式 | ProA affinity purified |
| 性状 | Liquid |
| 缓冲液 | 1*TBS (pH7.4), 1%BSA, 40%Glycerol. Preservative: 0.05% Sodium Azide. |
| 研究背景 | Lipopolysaccharide (LPS) elicits the secretion of mediators and cytokines produced by activated macrophages and monocytes. CD14 is a glycosylphosphatidylinositol (GPI)-anchored protein found on the surfaces of monocytes and polymorphonuclear leukocytes. CD14 functions as a receptor for LPS, resulting in the secretion of various proteins. An important component in the LPS activation of monocytes through the CD14 receptor is the "adapter molecule," lipopolysaccharide binding protein (LBP). There are two forms of CD14, a membrane-associated form (mCD14), and a soluble form (sCD14). mCD14 responds to LPS alone and facilitates the secretion of proteins, while cells not expressing mCD14 fail to respond to LPS. The cells that lack mCD14 respond to LPS/LBP in the presence of sCD14. |
| 偶联 | Unconjugated |
| 免疫原 | Recombinant Protein |
| Uniprot ID |
| 分子量 | Theoretical: 55-65 kDa. |
| 储存方式 | Store at -20°C or -80°C for 12 months. Avoid repeated freeze-thaw cycles. |
| 运输方式 | Shipping with blue ice. |